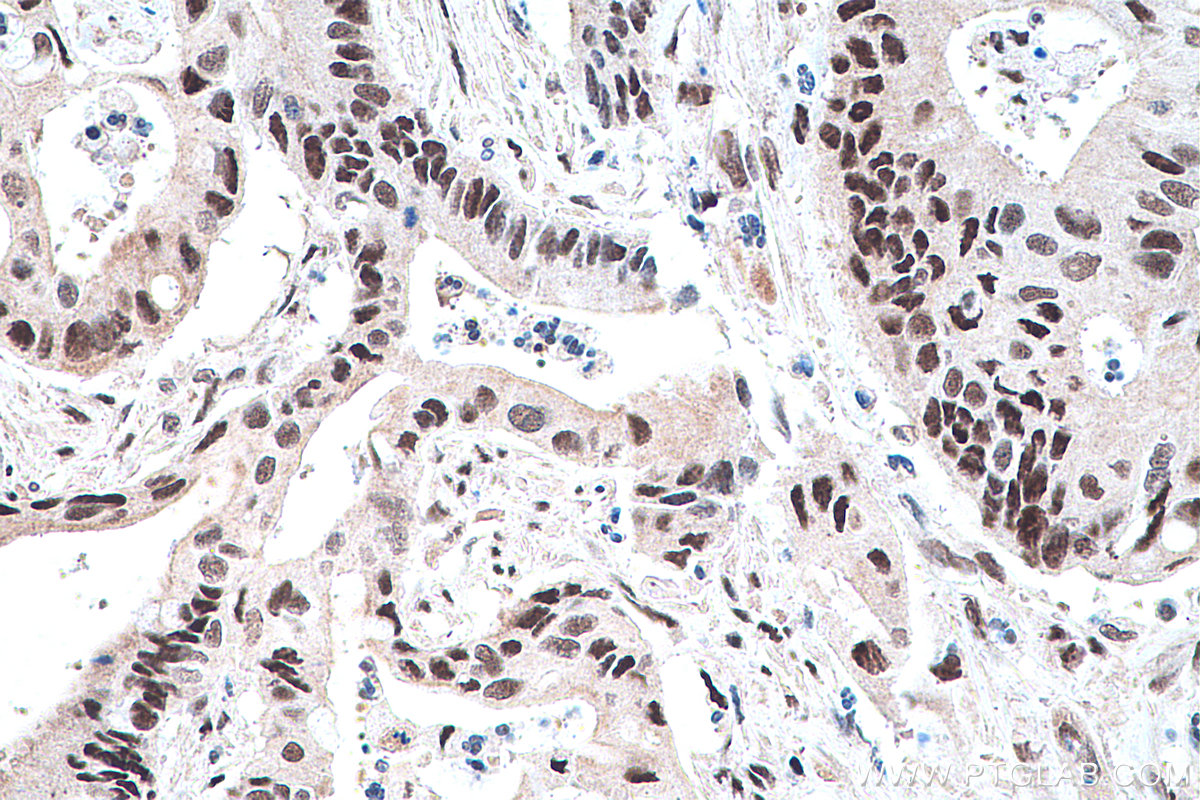

验证数据展示
经过测试的应用
| Positive WB detected in | HL-60 cells, THP-1 cells |
| Positive IHC detected in | human prostate cancer tissue, human colon cancer tissue, mouse colon tissue, rat colon tissue, human placenta tissue Note: suggested antigen retrieval with TE buffer pH 9.0; (*) Alternatively, antigen retrieval may be performed with citrate buffer pH 6.0 |
| Positive IF-P detected in | human colon tissue |
| Positive IF/ICC detected in | HeLa cells |
推荐稀释比
| 应用 | 推荐稀释比 |
|---|---|
| Western Blot (WB) | WB : 1:1000-1:6000 |
| Immunohistochemistry (IHC) | IHC : 1:4000-1:16000 |
| Immunofluorescence (IF)-P | IF-P : 1:200-1:800 |
| Immunofluorescence (IF)/ICC | IF/ICC : 1:200-1:800 |
| It is recommended that this reagent should be titrated in each testing system to obtain optimal results. | |
| Sample-dependent, Check data in validation data gallery. | |
产品信息
60127-1-Ig targets PPAR Gamma in WB, IHC, IF/ICC, IF-P, ELISA applications and shows reactivity with human, mouse, rat samples.
| 经测试应用 | WB, IHC, IF/ICC, IF-P, ELISA Application Description |
| 文献引用应用 | WB, IHC, IF |
| 经测试反应性 | human, mouse, rat |
| 文献引用反应性 | human, mouse, rat, zebrafish, sheep |
| 免疫原 |
CatNo: Ag10005 Product name: Recombinant human PPARG protein Source: e coli.-derived, PGEX-4T Tag: GST Domain: 161-477 aa of BC006811 Sequence: KCQYCRFQKCLAVGMSHNAIRFGRMPQAEKEKLLAEISSDIDQLNPESADLRALAKHLYDSYIKSFPLTKAKARAILTGKTTDKSPFVIYDMNSLMMGEDKIKFKHITPLQEQSKEVAIRIFQGCQFRSVEAVQEITEYAKSIPGFVNLDLNDQVTLLKYGVHEIIYTMLASLMNKDGVLISEGQGFMTREFLKSLRKPFGDFMEPKFEFAVKFNALELDDSDLAIFIAVIILSGDRPGLLNVKPIEDIQDNLLQALELQLKLNHPESSQLFAKLLQKMTDLRQIVTEHVQLLQVIKKTETDMSLHPLLQEIYKDLY 种属同源性预测 |
| 宿主/亚型 | Mouse / IgG1 |
| 抗体类别 | Monoclonal |
| 产品类型 | Antibody |
| 全称 | peroxisome proliferator-activated receptor gamma |
| 别名 | PPARG, PPARγ, PPAR-gamma, Peroxisome proliferator-activated receptor gamma, NR1C3 |
| 计算分子量 | 58 kDa |
| 观测分子量 | 66-70 kDa |
| GenBank蛋白编号 | BC006811 |
| 基因名称 | PPARG |
| Gene ID (NCBI) | 5468 |
| RRID | AB_2166065 |
| 偶联类型 | Unconjugated |
| 形式 | Liquid |
| 纯化方式 | Protein G purification |
| UNIPROT ID | P37231 |
| 储存缓冲液 | PBS with 0.02% sodium azide and 50% glycerol, pH 7.3. |
| 储存条件 | Store at -20°C. Stable for one year after shipment. Aliquoting is unnecessary for -20oC storage. |
背景介绍
Peroxisome Proliferator-Activated Receptors (PPARs) are ligand-activated intracellular transcription factors, members of the nuclear hormone receptor superfamily (NR), that includes estrogen, thyroid hormone receptors, retinoic acid, Vitamin D3 as well as retinoid X receptors (RXRs). The PPAR subfamily consists of three subtypes encoded by distinct genes denoted PPARα (NR1C1), PPARβ/δ (NR1C2) and PPARγ (NR1C3), which are activated by selective ligands. PPARγ, also named as PPARG, contains one nuclear receptor DNA-binding domain and is a receptor that binds peroxisome proliferators such as hypolipidemic drugs and fatty acids. It plays an important role in the regulation of lipid homeostasis, adipogenesis, INS resistance, and development of various organs. Defects in PPARG are the cause of familial partial lipodystrophy type 3 (FPLD3) and may be associated with susceptibility to obesity. Defects in PPARG can lead to type 2 INS-resistant diabetes and hypertension. PPARG mutations may be associated with colon cancer. Genetic variations in PPARG are associated with susceptibility to glioma type 1 (GLM1). PPARG has two isoforms with molecular weight 57 kDa and 54 kDa (PMID: 9831621), but modified PPARG is about 67 KDa (PMID: 16809887). PPARG2 is a splice variant and has an additional 30 amino acids at the N-terminus (PMID: 15689403). Experimental data indicate that a 45 kDa protein displaying three different sequences immunologically related to the nuclear receptor PPARG2 is located in mitochondria (mt-PPAR). However, the molecular weight of this protein is clearly less when compared to that of PPARG2 (57 kDa). (PMID: 10922459). PPARG has been reported to be localized mainly (but not always) in the nucleus. PPARG can also be detected in the cytoplasm and was reported to possess extra-nuclear/non-genomic actions (PMID: 17611413; 19432669; 14681322).
发表文章
| Species | Application | Title |
|---|---|---|
Front Pharmacol Bushen Huoxue formula attenuates lipid accumulation evoking excessive autophagy in premature ovarian insufficiency rats and palmitic acid-challenged KGN cells by modulating lipid metabolism | ||
Int Immunopharmacol Therapeutic potential of palmitoleic acid in non-alcoholic fatty liver disease: Targeting ferroptosis and lipid metabolism disorders | ||
Front Pharmacol Resveratrol prevents gallstones in mice fed on a high fat diet via regulating PPAR-γ and SR-BI | ||
J Physiol Biochem miR-128-3p regulates 3T3-L1 adipogenesis and lipolysis by targeting Pparg and Sertad2. | ||
Food Funct CD36 and DGAT2 facilitate the lipid-lowering effect of chitooligosaccharides via fatty acid intake and triglyceride synthesis signaling. | ||
J Immunol Res Identification of Adipogenesis Subgroups and Immune Infiltration Characteristics in Diabetic Peripheral Neuropathy |